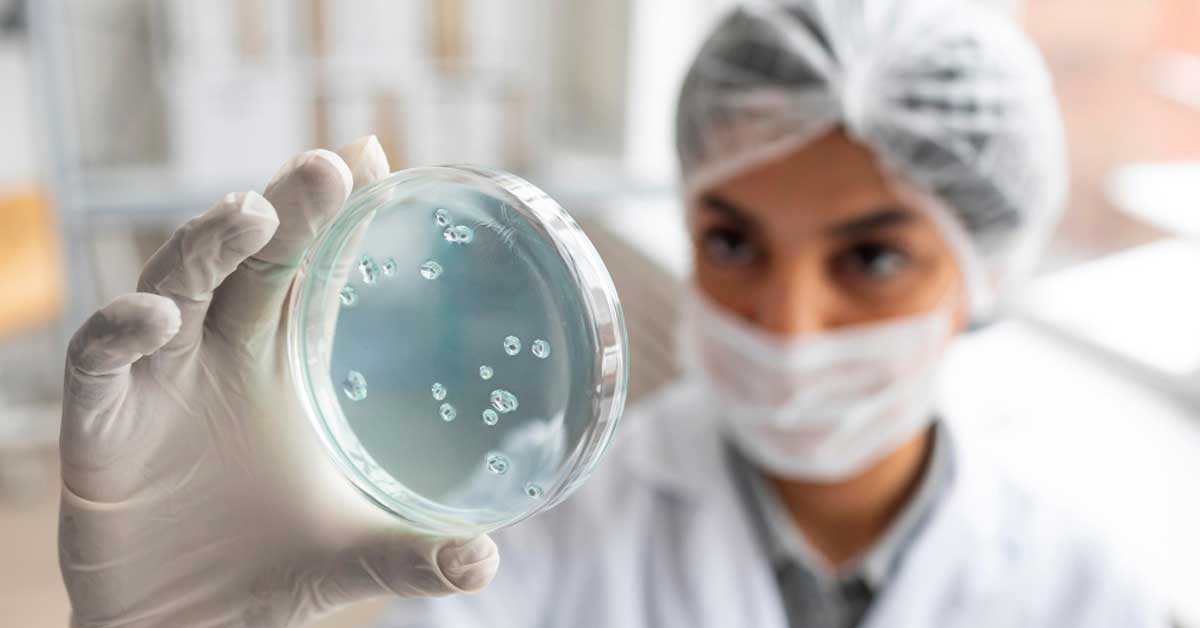

·23 Views
·0 Reviews
-
-
https://qualitysmartsolutions.com/blog/what-are-critical-control-points-in-haccp/·187 Views ·0 Reviews
-
https://qualitysmartsolutions.com/blog/achieving-gras-status-for-a-probiotic-a-step-by-step-approach/·174 Views ·0 Reviews
More Stories